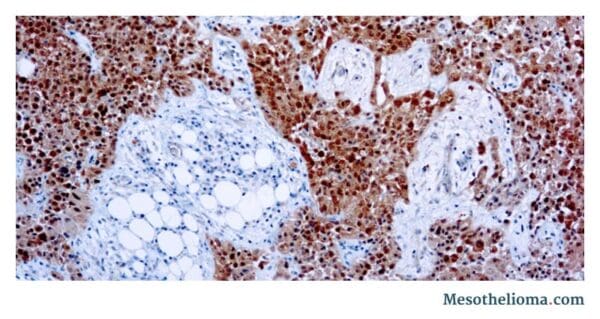
Epithelial cells with calretinin stain under a microscope

Epithelioid Mesothelioma
Epithelioid mesothelioma is a cancer caused by asbestos. The epithelial cell subtype is the most common mesothelioma cell type, accounting for 50% – 70% of cases. With treatment, life expectancy generally ranges from 1.5 to 6.5 years, depending on tumor location. Survival with epithelioid mesothelioma may be slightly better than with rarer cell types.
Request a Free Epithelioid Mesothelioma Guide

What Is Malignant Epithelioid Mesothelioma?
Epithelioid mesothelioma is a form of malignant mesothelioma made up of epithelioid cells. It is a form of cancer caused by asbestos.
Epithelial cells make up one of four types of tissues naturally found in the body. Epithelial tissue is located on the skin’s surface, in the linings of hollow organs and blood vessels and along the lining of internal cavities.
When an individual is exposed to asbestos fibers, epithelial cells can mutate and become cancerous. Epithelioid mesothelioma is the most common form of the disease. The cell type is found in about 50% – 70% of all mesothelioma cancer patients.
Some important facts about epithelioid mesothelioma include:
- It is the most common mesothelioma cell type.
- 50% to 70% of all mesothelioma cases are epithelioid.
- It responds well to treatment compared to other cell types.
- This type commonly qualifies for multimodal treatment.
- With treatment, survival ranges from 18 months to more than 3 years.
- Epithelioid cells can be a variety of shapes, including cubed, columnar and squamous (flat).
Squamous cells are commonly found in the lining of the lungs, also known as the pleura. Epithelioid mesothelioma cells are also recognizable compared to other mesothelioma cell types because of how they adhere to each other. The cells form in small clusters and may be round or oval. The cells can also be identified by their visible nuclei.
Epithelioid cells typically divide faster than other cells. However, the way the cells form in clusters may make them slower to spread compared to other cell types.
Epithelial Mesothelioma Symptoms
Malignant epithelioid mesothelioma can present with a variety of symptoms, depending on where the cancer develops. The presence and severity of symptoms also depend on cell type and the patient's age, overall health and stage at diagnosis.
Epithelioid mesothelioma patients may not experience severe symptoms until a later stage of disease. Fever and fluid buildup around the lungs or in the abdomen are common symptoms of epithelioid mesothelioma.
- Chest pain
- Coughing and hoarseness
- Difficulty breathing (dyspnea)
- Fever
- Fluid buildup around the lungs (pleural effusion)
- Unexplained weight loss
- Abdominal pain
- Abdominal swelling
- Constipation
- Fever
- Fluid buildup in the abdomen (peritoneal effusion)
- Loss of appetite and weight loss
What Causes Epithelioid Mesothelioma?
Asbestos exposure causes epithelioid mesothelioma. When someone breathes in or swallows asbestos fibers, they can get trapped in the body. Over time, the fibers may reach the mesothelial cells that line some organs and body cavities.
The fibers irritate the cells and trigger ongoing inflammation and damage. Over time, this can cause the cells to mutate into cancer. If the affected cells are epithelial-shaped, then epithelioid mesothelioma is the result. The time frame from exposure to the onset of cancer is usually between 10 and 50 years.
Epithelial Mesothelioma Diagnosis
Doctors use several steps to diagnose epithelioid mesothelioma. The process typically includes:
- Imaging tests like X-rays, CT scans, MRIs or PET scans to look for tumors or other abnormalities
- Blood tests to check for biomarkers linked to mesothelioma or other conditions
- A biopsy to remove a small tissue sample, which may be done with or without surgery
- Lab testing to examine the sample and identify the type of cells present
Immunohistochemistry for Diagnosing Epithelioid Mesothelioma
Guidelines recommend immunohistochemistry (IHC) testing as a way to confirm an epithelioid mesothelioma diagnosis. It is a staining technique that can identify cell type and differentiate mesothelioma from other cancers, such as adenocarcinoma.
Sarcomatoid cells may also be present in these samples, which can indicate biphasic mesothelioma.
Certain antibodies can help identify epithelioid mesothelioma in patients. When these antibodies are applied in combination, they can help a pathologist accurately diagnose the disease.
Immunohistochemical Markers Used in Diagnosing Epithelioid Mesothelioma
The presence of epithelioid mesothelioma markers supports a diagnosis of epithelioid mesothelioma. Markers of epithelioid mesothelioma include:
- Calretinin: Present in almost all epithelioid mesotheliomas
- Cytokeratin: Present in 70% to 95% of mesotheliomas
- Podoplanin (D2-40): Present in 90% to 100% of mesotheliomas
Source: Archives of Pathology & Laboratory Medicine
The presence of lung adenocarcinoma markers may help rule out a diagnosis of epithelioid mesothelioma. Markers of lung adenocarcinoma include:
- Claudin 4: Present in almost all lung adenocarcinomas and absent in mesotheliomas
- CEA: Present in 80% to 100% of lung adenocarcinomas
- MOC31: Present in 95% to 100% of lung adenocarcinomas
Epithelioid Mesothelioma Prognosis
A patient’s cell type also plays a role in prognosis. Patients with epithelioid cancer cells have a more favorable prognosis and overall life expectancy than those with other cell types. In general, patients with epithelioid mesothelioma survive 1.5 – 6.5 years.
Because epithelial mesothelioma is often more responsive to treatment than other mesothelioma cell types, getting an accurate and timely diagnosis can directly impact a patient’s treatment options and long-term outlook.
 Vincent Mase, MD
Vincent Mase, MD
One 2017 study examined the survival of pleural mesothelioma patients with the epithelioid cell type. The study also included patients with sarcomatoid and biphasic cell types. Researchers found the following median survivals for patients treated with multimodal therapy:
- Epithelial mesothelioma: ~23 months
- Biphasic mesothelioma: ~14 months
- Sarcomatoid mesothelioma: ~11 months
The prognosis for epithelioid mesothelioma depends on many factors, including the location and stage of mesothelioma. Doctors also consider the patient’s age, general health and pre-existing conditions.
What Is the Survival Rate for Epithelioid Mesothelioma?
Survival rates for epithelioid mesothelioma vary by patient. They depend on factors like the stage at diagnosis and the type of treatment used. In a study, epithelioid mesothelioma survival rates were 66% – 68% at 1-year follow-up.
- 1-year: 68%
- 2-year: 42%
- 1-year: 66%
- 2-year: 33%
Source: The Lancet
The findings above show how the treatment approach can impact survival. You can discuss treatment options with a mesothelioma specialist. The doctor can help you understand which approaches work best for your condition and goals.
Epithelioid Mesothelioma Treatment
Epithelioid mesothelioma treatment may include surgery, chemotherapy and radiation therapy. Epithelial cells may be more susceptible to chemotherapy than sarcomatoid cells, making the treatment more effective. In many cases, patients will undergo a multimodal treatment plan, which is when two or more treatment methods are combined. Some procedures can also be used as palliative treatments, which can lessen symptoms for patients.
| Pleural | Peritoneal | |
|---|---|---|
| Checkpoint Inhibitor Immunotherapy | ~19 months | More than 39 months* |
| Chemotherapy | ~17 months | Not reported |
| Surgery + Heated Chemotherapy | ~42 months | 79 months |
*Patients received a checkpoint inhibitor after systemic chemotherapy
Sources: The Lancet, Journal of Clinical Oncology, Journal of Thoracic Oncology, Cancer
Common Treatment Options
Various other mesothelioma treatment options may be used alone or as part of a multimodal plan. These combined methods usually offer the best chances at improving survival and quality of life. Depending on the patient’s needs and eligibility, common approaches include:
- Surgery: Some patients may be a good fit for procedures to remove tumors, such as pleurectomy/decortication (P/D) or extrapleural pneumonectomy (EPP). Surgery is often part of a larger treatment plan. In a recent study, patients with epithelial tumors lived about 42 months after surgery and heated chemotherapy.
- Immunotherapy: This helps the immune system recognize and attack cancer. Immune checkpoint inhibitors (ICI) are commonly used, especially for patients who cannot have surgery. Popular ICIs for mesothelioma include Opdivo® (nivolumab) and Yervoy® (ipilimumab).
- Chemotherapy: This standard treatment uses drugs to kill cancer cells or slow their growth. It can be used alone or combined with surgery or immunotherapy. The drug Avastin® (bevacizumab) may boost chemo’s cancer-fighting power. One study with chemo+Avastin improved survival by 3 months compared to chemo alone.
- Radiation therapy: This approach uses energy to kill cancer cells. It is most often used alongside other treatments rather than on its own. In one study, epithelioid patients who underwent surgery-based treatment and radiation had a median survival of about 3.5 years.
- Emerging treatments: Researchers are exploring newer options like gene therapy, photodynamic therapy and targeted drug approaches. Patients may access promising methods not yet widely available through clinical trials.
Rare Subtypes of Epithelial Mesothelioma
Pathologists have identified several rare subtypes of epithelial mesothelioma, but they don’t have proper names. Instead, these rare subtypes are described by the individual cell’s appearance (cytological features) and the structures formed by groups of cells (architectural patterns).
Rare cell subtypes of mesothelioma may have the following shapes and patterns:
Cell Appearance (Cytological Features)
- Clear cell: Large, round cells with transparent inner fluid
- Deciduoid: Cells with abundant inner fluid that look like placenta cells
- Lymphohistiocytoid: A mixture of polygon-shaped tumor cells and immune cells
- Pleomorphic: Irregularly shaped cells with one or more non-spherical centers (nuclei)
- Rhabdoid: Individual cells with generous inner fluid and off-center nuclei
- Signet ring: Cells with transparent bubble-like structures that push their nuclei to one side
- Small cell: Petite cells with large centers
Cell Group Structures (Architectural Patterns)
- Adenomatoid: Groups of cells that look like lace
- Micropapillary: Free-floating groups of cells that look like fingers
- Solid: Groups of cells that tightly attach to each other in sheets
- Trabecular: Groups of cells in thin cords or single file lines
- Tubulopapillary: Groups of cells that look like fingers and glands
According to experts, some characteristics may signal better prognosis than others.
- Linked to better prognosis: Lymphohistiocytoid cells and tubulopapillary, trabecular and adenomatoid patterns
- Linked to worse prognosis: Pleomorphic and rhabdoid cells, solid and micropapillary patterns
Common Questions About Epithelioid Mesothelioma
Is epithelioid mesothelioma a type of malignant mesothelioma?
How does a mesothelioma cell type affect my prognosis and treatment?
Sources
Free Epithelioid Mesothelioma Treatment Guide


Katy Moncivais, Ph.D., has more than 15 years of experience as a medical communicator. As the Medical Editor at Mesothelioma.com, she ensures our pages and posts present accurate, helpful information.

Dr. James Stevenson is a Board-Certified Medical Oncologist. He specializes in treating mesothelioma and lung cancer and practices at the Cleveland Clinic in Cleveland, Ohio.


